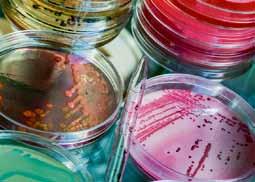

4 Ειδήσεις
6
8 Γιατί
10
11
12
14 Δώστε "πνοή"... στον ύπνο σας!
16 Διασκεδάστε ...καίγοντας θερμίδες!
18 "Κότσι": Τελικά το χειρουργείο είναι η μοναδική κατάληξη;
20 Φυματίωση:
22
24
26
CEO: ΚΩΝΣΤΑΝΤΙΝΟΣ ΟΥΖΟΥΝΗΣ ouzounis.k@ethosmedia.eu ΑΡΧΙΣΥΝΤΑΞΙΑ:
kaniouras.s@ethosmedia.eu
svolou.a@ethosmedia.eu
gerasimou.v@ethosmedia.eu
bassea.g@ethosmedia.eu
charalampakis.c@ethosmedia.eu ΛΩΡΕΤΤΑ
boura.l@ethosmedia.eu ΥΠΟΔΟΧΗ
ΔΕΣΠΟΙΝΑ ΡΟΠΟΔΗ ropodi.d@ethosmedia.eu
MARkETIng-ΕΠΙΚΟΙΝωΝΙΑ & ΔΗΜΟΣΙΕΣ
ΑΘΗΝΑ ΦΡΑΔΕΛΟΥ fradelou.a@ethosmedia.eu ΣΟΦΙΑ-ΑΦΡΟΔΙΤΗ ΒΟΥΛΓΑΡΑΚΗ voulgaraki.s@ethosmedia.eu
ΥΠΕΥΘΥΝΟΣ ΣΥΝΔΡΟΜωΝ & ΚΥΚΛΟΦΟΡΙΑΣ:
lazarakou.n@ethosmedia.eu
ShutterStock



















το βρα -
δινό βούρτσισμα είναι
απαραίτητο, γιατί τη
νύχτα, λόγω της στά -
σης του σάλιου (δεν
παράγεται σάλιο), δεν
ξεπλένεται το στόμα.
Μείωση της συχνό -
τητας κατανάλωσης


Σύμφωνα
με την
Αμερικανική
Ακαδημία
Κοσμητικής
Οδοντιατρικής, το 92% των
ενηλίκων
θεωρεί ότι το
ελκυστικό
χαμόγελο
παίζει
σημαντικό
ρόλο στις
κοινωνικές
σχέσεις, ενώ το 75%
συμφωνεί ότι
ένα ελκυστικό
χαμόγελο
μπορεί να
αυξήσει
τις επαγγελμα -
τικές επιτυχίες







Ευαισθησία
των δοντιών
και διάβρωση
του σμάλτου
τους, αιμορραγία
των ούλων, τερηδόνα, στεγνό στόμα

και δυσάρεστη
αναπνοή
αποτελούν καθημερινές ενοχλήσεις
για πολλούς
ανθρώπους, που ωστόσο αντιμετωπίζονται αποτελεσματικά
με τα
κατάλληλα προϊόντα